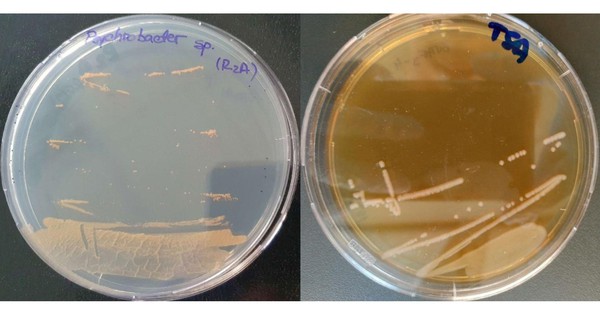
Sinh vật cực nguy hiểm ra từ băng hang động 5.000 năm

Liên quan đến vụ tai nạn giao thông đường thủy làm 6 người tử vong tại hồ Thác Bà xảy ra ngày 21-2 tại địa phận thôn Làng Cạn, xã Bảo Ái, tỉnh Lào Cai, Cơ quan Cảnh sát điều tra, Công an tỉnh Lào Cai đã ra quyết định khởi tố bị can và lệnh bắt bị can để tạm giam đối với lái tàu chở đá là Nguyễn Văn Thâm (SN 1984, trú tại thôn Mỏ Quan, xã Cảm Nhân) về tội "Vi phạm quy định về điều khiển phương tiện giao thông đường thủy".

Nguyễn Văn Thâm tại cơ quan công an. Ảnh: Công an cung cấp
Theo tài liệu của cơ quan điều tra, ngày 21-2, Nguyễn Văn Thâm được Công ty Cổ phần khoáng sản Marble Việt Nam phân công làm thuyền trưởng điều khiển tàu chở đá biển số YB-0919H.
Khoảng 17 giờ cùng ngày, Thâm cùng máy trưởng Nguyễn Mạnh Cường (SN 1979, trú tại thôn Đào Kiêu 1, xã Yên Bình) điều khiển tàu xuất phát từ bến tập kết tại thôn Mỏ Quan, xã Cảm Nhân trên hồ Thác Bà, di chuyển về bến của Công ty Cổ phần xi măng Yên Bình.
Đến khoảng 18 giờ, trời tối dần và xuất hiện sương mù nhẹ làm hạn chế tầm nhìn. Mặc dù đã bật đèn hành trình và đèn cảnh báo, Thâm không bật đèn pha chiếu sáng, không phát âm hiệu, tín hiệu theo quy định và không bố trí người cảnh giới tại các vị trí cần thiết trên phương tiện.
Khoảng 18 giờ 45 phút, khi tàu đi đến khu vực thôn Làng Cạn, xã Bảo Ái, Thâm phát hiện phía trước có một phương tiện di chuyển ngược chiều. Đó là tàu khách biển số YB-0876H do Triệu Văn Nội (SN 1995, trú tại thôn Suối Hốc, xã Cảm Nhân) điều khiển. Hai bên đã điều khiển phương tiện để tránh nhau, tuy nhiên do khoảng cách gần và tầm nhìn hạn chế, mạn trái phần đuôi tàu YB-0876H đã va vào góc lưỡi phà bên trái của tàu YB-0919H, khiến tàu khách bị lật, làm 6 người tử vong.

Nguyễn Văn Thâm tại cơ quan công an. Ảnh: Công an cung cấp
Được biết, tàu chở khách gặp nạn khi đang trên đường chở hơn 20 người cùng thôn, trong đó có nhiều người có quan hệ ruột thịt, họ hàng đi chúc Tết về.
Hiện, vụ tai nạn giao thông đường thủy đặc biệt nghiêm trọng đang được cơ quan chức năng tiếp tục điều tra, làm rõ để xử lý theo quy định của pháp luật.

 2 hours ago
1
2 hours ago
1

English (US) ·
English (US) ·